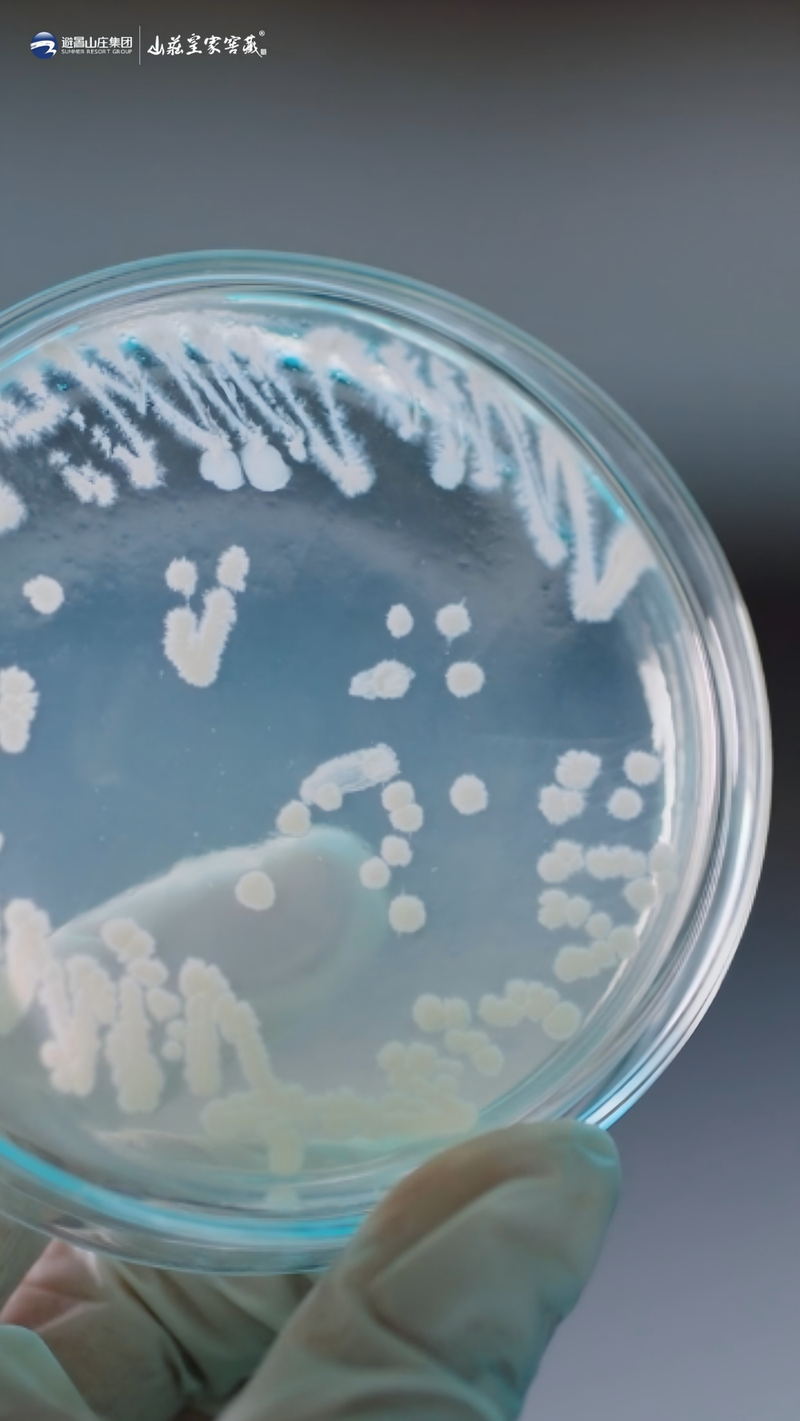
图片

开窖启新酿,百亿赴新程。
文|好酒地理局
“2026年,白酒行业正加速进入竞争‘选择’新阶段,决定‘选择’的核心因素是文化,具体表现在文化坚守、文化共创、文化审美。”
对山庄集团而言,文化不仅是品牌故事,更是实现其百亿目标的底气。
在4月20日举办的山庄·2026中国皇家酒文化开窖节上,中国酒类流通协会会长秦书尧提出,山庄集团拥有深厚的皇家酒文化积淀,如何汲取精髓,创新消费场景、升级消费体验,让皇家文化在新时代焕发新活力,值得所有人关注与期待。
借助此次开窖节,山庄集团为中国白酒的文化表达,树立了极具特色的优秀标杆。
“对于山庄而言,开窖从来不是一次简单的生产启动,而是一场跨越三百年的文化传承,一次与历史的深情对话,一份对消费者的庄严承诺。”
据山庄集团党委书记、董事长尤文武介绍,自清代“涌泰泉”烧锅创立以来,谷雨开窖既为送春,亦为敬春,这一规矩代代相传。
以深厚文化为基石,以硬核品质为支撑,山庄集团正在走出“冀酒百亿龙头”的强有力步伐。

为何是平泉?
“源起于炎帝、大成于仪狄、兴建于契丹、成名于康熙、发展到现代”,在阐述百亿战略目标时,山庄集团销售公司总经理张建强调,山庄酒的品牌高度,在于悠久的酿造历史,以及不可复制的皇家文化。
康熙五十六年(1717年)秋,直隶巡抚赵弘燮上了一道折子。宣化府百姓请求朝廷网开一面,准许他们像热河那样开设烧锅、酿造烧酒。
康熙帝的批复很简练:“热河烧锅一事,乃地方有司,当禁当开,即可行去。从来未经传旨开禁。”
短短几句话,道出了一个特殊事实。在整个北方都在禁酒的大环境里,热河是一块飞地。
与以往各朝禁酒多出于“防止臣民饮酒坏德”目的不同的是,清朝禁酒主要是为了保障粮食供应,基本规律为:“歉年行禁,丰年弛禁,歉收之地行禁,丰收之地弛禁。”
位于热河东北隅的平泉市(当时叫八沟),正是“可弛之地”。此地位于河北省承德市东部,东接辽宁凌源,北连内蒙古宁城,南靠宽城,处在冀、辽、蒙三地交界。

制图@好酒地理局
当地水源优质,街心泉水平地涌出,甘甜清澈,康熙十六年(1677年),康熙北巡路过平泉,见平地泉水涌出,随口赞曰“圣地平泉”,也有说法康熙赞叹的是“平地涌泉,好个所在”。
与此同时,这里粮食丰足,盛产高粱小麦,旧时就有“拉不败的哈达,填不满的八沟”之誉。
水好、粮足,酒便有了根。酿酒业在此兴起,并非偶然。
顺治元年(1644年),张氏家族在此立起涌泰泉烧锅,拉开了平泉有文字可考的酿酒史。
相传康熙二十年(1681年),康熙帝出喜峰口巡游蒙古诸部,驻跸平泉党坝大吉口,以当地所酿“八沟老酒”犒赏蒙古各部,举行“塞上宴诸藩”,所用之酒出自平泉涌泰泉烧锅。

▎作为山庄集团的前身之一,“涌泰泉”的古窖池留存至今。
彼时热河仍属边地,但这杯酒已凭醇厚口感入了帝王之选,为日后繁盛埋下伏笔。
康熙四十二年(1703年),清廷在武烈河西岸的狭长谷地上破土动工,开始兴建热河行宫(即避暑山庄)。一座庞大宫苑拔地而起,彻底改变了这片土地的面貌。
皇帝每年夏天来避暑,秋日去围场打猎,随行的王公大臣数以千计,吃饭喝酒都是大事。从京城运酒路途遥远,不如就地解决,当地的烧锅就这样担起了供应行宫用酒的差事。
康熙五十年(1711年),承德行宫初步建成,康熙特取涌泰泉“八沟老酒”宴群臣,御封“山庄老酒”,并将其藏入山庄恒温恒湿的酒洞——上用库。
此后,涌泰泉承担贡酒之任,并分建“信合成”烧锅,专司民间高粱老酒。
晚清时期,随着清廷财政紧张,避暑山庄的修缮逐渐停滞,直隶总督李鸿章奏请改革酒税,将征收权下放州县,热河烧锅自此也成为纳税商户。
他们修筑武烈河堤坝,筹银赈灾,渐渐融入地方社会。

到了民国初年,当地仍保留着一种独特的交易方式:春夏之交,烧锅将酒分运各乡,赊与百姓;待秋收之后,再派人收粮抵账。以粮换酒,已深深嵌入日常。
1948年,平泉第二次解放。不久,当地政府把涌泰泉、信合成、涌泉长、天泰泉、广和涌等数十家旧烧锅合并,建起平泉县酿酒厂,几位老烧锅酒师——刘坤、于怀、李月芝、刘玉荣进厂传艺。
三年后,他们靠着记忆反复试验,终于酿出第一桶白酒,外观和味道都与当年的平泉老酒一致。
1979年,酒厂开发出白酒新品种,因厂址毗邻避暑山庄,正式命名山庄老酒。
末代皇帝溥仪的胞弟溥杰题诗“故苑八珍传御宴,平泉河北诩山庄”。
2008年,山庄老酒酿造技艺列入国家级非物质文化遗产名录。这套技艺的核心工序,康熙年间已在供酒的涌泰泉烧锅里定型。为皇家供酒的身份,让它在选粮、窖藏、品质把控上比民间烧锅多了一套严苛的规矩。

制图@好酒地理局
又是一年春夏之交。
三百年皇家酒脉,不只是历史的回响,更是山庄集团冲刺百亿目标最深厚的底气。
正是这种不可复制的文化资产,让山庄老酒在消费者心中形成了独特的价值占位。
而今天的山庄集团,正在用更加科学的语言,解释这个“皇家白酒”,好在哪里。

科技护城河
实现百亿目标,品质是基石,科技是引擎。
山庄集团深知,没有硬核品质支撑,文化就只是空中楼阁。而这一切,首先从平泉得天独厚的生态环境说起。
“平泉森林覆盖率达58.5%,空气优良天数超300天,被誉为‘华北绿肺’,这种纯净、高负氧离子的环境,为酿酒微生物的繁衍提供了天然温床。”

▎丰富的森林植被为酿酒微生物的繁衍栖息营造了天然温床,良好的微生物多样性为酿造高品质的山庄老酒奠定了坚实基础。
据山庄集团技术质量中心国家级评委范春孟介绍,平泉依托72处泉眼与5河发源地,采用280米深层岩层裂隙承压水,水质甘洌纯净,pH值呈弱碱性,富含钾、镁、锌、硒等十几种有益微量元素。
除了宏观酿酒环境外,集团也持续通过微观层面深入探索好酒密码。
在开窖节活动现场,山庄集团技术质量中心总监王国明发布了《山庄·2026科技创新品质提升白皮书》并指出,作为拥有三百余年皇家酒脉的中华老字号,山庄集团坚守“守正创新”理念,以“绿色产区生态与酿造微生态双导向、产品风味与健康双属性”为科研方向,实现传统酿造与现代科技深度融合。

自2010年起,山庄集团成立了酿酒微生物技术创新中心,并与天津科技大学、中国食品检测中心、中国工业微生物菌种保藏中心等权威机构建立了紧密合作。
酿酒微生物技术创新中心引入宏基因组学技术,全面解析山庄老酒发酵过程的微生态体系。
截至目前,团队通过宏基因组技术解析出山庄皇家窖藏酿造微生态中存在着8258种微生物。王国明谈道:“这在国内白酒行业的公开报道中,是发酵种属最多、最复杂的微生态环境。”
此外,还从中分离筛选了460余株优势菌株,建立了专属菌种资源库与数字信息库。尤其值得一提的是,从涌泰泉清代小窖泥池中,功能微生物的丰度是新窖池的三倍以上。
这印证了老窖池的价值,在于时间赋予微生物群落的独特结构。
围绕消费者最关心的醒酒快、不口干,研究团队鉴定出核苷类、γ-氨基丁酸等十二种具有解酒功效的健康因子。
数据很有说服力:保护肝功能的腺苷含量达433.5毫克每升,促进酒精分解的γ-氨基丁酸含量0.867毫克每升,抗氧化吡嗪类物质含量504.64微克每升,核苷类物质含量440.7毫克每升,是普通白酒的十倍到一百倍。
同时,采用感官风味组学技术,定性出山庄皇家窖藏酒富含1032种风味物质,证实己酸、十二烷酸乙酯是复合玫瑰香的关键成分。
高酯、高酸、低醇的风味特征,被科学技术一一证实。

在解决白酒上头这个行业痛点方面,山庄筛选出一株获得国家自主知识产权的高产酯、低产杂醇油优势酵母菌。
这项技术让总酯提升了15.1%,高级醇含量降低了30%,出酒率提升12%,优级品率提高20%。技术成果被评价为国际领先水平。
此外,研究团队还率先引入团簇分子理论,解释陶坛储存如何让酒体分子抱团,从而降辛增柔。
在不断更新科学表达的同时,山庄也始终没有丢掉对传统酿造的敬畏。
今年开窖节,除了礼敬天地、感恩先祖的祭祀活动,还有一个特别的环节——山庄集团携手周恒刚酿酒科学文化研究院同步进行了《周恒刚传》采访暨#中国白酒科学文化考察 走进山庄启动仪式。

20世纪70年代,这位白酒泰斗曾亲临平泉一线,参与山庄老酒的试车生产;80年代,他又对“低度山庄老酒”的研制给予现场指导。
如今启动《周恒刚传》采访暨#中国白酒科学文化考察 走进山庄活动,正是把这段跨越半个世纪的历史渊源正式挖掘出来,为山庄的“科技酿酒”找到了历史源头。
山庄的酿造底色,一半是三百多年的皇家窖池与传统酿造技艺,一半是显微镜下的微生物世界。
这种“传承不守旧,创新不离根”的发展模式,最终让山庄的科技智造与极致生态、深厚文化融为一体,共同定义了“中国皇家白酒第一品牌”的新内涵。

面向“十五五”的开局之年,山庄集团并没有满足于已有的成果。王国明提到,接下来的科技创新将围绕四个维度展开。
聚焦低醉酒度和健康因子这些核心领域,与高校、协会形成更深度的协同创新。
通过结合宏观参数与微观多组学数据,建立生产品质标准化体系,实现“经验酿酒”向“科学酿酒”跨越
聚焦“玫瑰香”定向调控,建立风险物质预警体系,厘清风味与健康的酿造机理,构建可视化表达体系,强化产品独特性与健康价值。
建立覆盖原粮、酿造、贮存、成品的溯源体系,以科学量化品质,用数据和标准把关,向消费者透明展示工艺与品质信息,提升品牌信任度。
正是这些扎实的科技创新与品质突破,为山庄集团的百亿目标构筑了不可撼动的护城河。
品质,不仅是百亿的底气,更是百亿之后持续领先的根基。
在找到自己的发展方向的同时,它也在寻找另一个更大命题的答案——冀酒振兴。

冀酒振兴
在中国白酒版图中,河北是一个独特的存在。
据河北省轻工行业协会公布的数据,2025年,全省白酒获生产许可证企业498家,其中规模以上企业28家。规模以上企业2025年度实现营业收入69.76亿元,利润总额8.34亿元,完成产量12.29万千升。
然而,一个长期困扰冀酒板块的结构性问题始终悬而未决:虽有丰富的白酒品类和酿酒底蕴,但尚未形成具有强大市场影响力和品牌认知度的统一产区品牌。
当下,冀酒振兴正在迎来一个时间窗口。
“冀酒的破局,关键在‘现在行动’”。中国酒业协会理事长宋书玉在2025年冀酒高质量发展圆桌会上,对冀酒寄予期待:“河北有700亿市场、有源头文化、有工艺根基,只要守住优势、补上短板,完全有能力重回全国前列。”

山庄老酒凭借营收与增速双料领先,成为冀酒中的黑马,与此同时,自2021年起连续举办的开窖节,向外界展示了冀酒企业从文化叙事与科技叙事两个维度上的完整表达。
2021年山庄开窖节上,尤文武明确提出营收50亿元,利税10亿元的目标,“皇家酒”文化与品牌势能形成合力。
2022年,开窖节以“皇家标准·醒酒更快”为主题,标志着山庄开始将品质认知从传统叙事向功能价值延伸,为其后数年科技路线的铺陈埋下了伏笔。
2023年是战略加速之年。开窖节上,山庄将百亿目标提上日程,提出百亿营收、利税20亿元的目标,比2021年的50亿元目标翻了一倍。同年,山庄集团启动总投资23.4亿元的第二酿造基地建设,为百亿战略布局产能底盘。
2024年,开窖节以“匠心科技·醒酒更快”为主题亮相,标志着山庄的战略重心发生关键转移。河北省科技厅颁发科技成果证书,食品行业生产力促进中心授予纯粮固态酿造示范基地牌匾,“醒酒更快研究院”正式揭牌成立。
开窖节不再仅仅是文化展演,而是成为山庄展示科研能力的舞台。匠心与科技并列为主题,传递出的信号是山庄的核心竞争力正在从历史底蕴转向技术壁垒。

▎位于山庄厂区内的研发中心
2025年,开窖节主题进一步演进为“高端好酒·醒酒更快”,围绕百亿目标同步夯实产能、产业与产区三大基础。
这一年,山庄集团取得了里程碑式的成果:第二酿造基地一期工程全面竣工,总投资23.4亿元、占地1000亩的智能化厂区为百亿战略筑牢了产能底座。
产能与产地两大基础同时落地,使百亿目标从愿景变为可执行的路线图。
2026年,开窖节以“开窖启新酿·百亿赴新程”为主题,发布了2030年实现销售规模100亿元、跻身中国白酒行业20强的战略目标。
张建表示,围绕这一目标,山庄集团同步推出了“三步跨越”的攻坚节奏与“六大引擎”驱动路径。
具体节奏为:2026到2027年夯实河北、启动周边,冲刺50亿;2028到2029年深耕河北、板块周边,跨越80亿;2030年领先河北、辐射周边,登顶100亿。

每一步都对应着产能、产品与市场的层层递进。
产品方面,山庄采取双香型并举策略,酱香1711与浓香30年树立价位标杆,窖藏系列全面覆盖从大众到高端的各个价位段;中高端核心单品窖藏12年锚定五百万件的高端宴席目标,八珍御酒则作为新品类开拓第二增长曲线。
市场方面,以河北为根据地,打造十五个超亿元县和多个过亿市区,同时聚焦北京、天津、赤峰、朝阳等环京津冀区域突破五亿元,电商渠道同步发力,目标同样锁定五亿元。
体系保障方面,山庄从品牌IP、客户运营、数字化和组织团队四维发力。全年四个节点打造开窖节、短视频挑战赛、拳王酒王争霸赛和皇家酒文化论坛,让消费者深度参与品牌共创。
经销商、终端、消费者三层客户运营体系配合数字化工具,实现千店千策和超级用户精准运营。十五大战区、三千人业务团队构筑起覆盖全省乃至周边市场的销售网络。
山庄集团的六年开窖节,是冀酒振兴进程中一个极具观察价值的样本。
每一次开窖,既是对一季窖藏时光的深情回望,亦是为冀酒振兴再启新程的庄严号角。
启封的不只是窖池中的岁月陈酿,更是山庄老酒乃至整个冀酒在千年酿酒传统里不断落下的创新印记。
# 推荐阅读 点击了解更多
参考资料:
[1]崔思朋,仲伟民.清代禁酒与粮食问题[J].重庆大学学报(社会科学版),2022,28(06):165-179.
[2]杨小敏.清代热河烧锅与承德酿酒业的兴起[J].河北民族师范学院学报,2023,43(01):6-11.
你怎么看山庄集团开窖节?
欢迎文末评论、点赞、分享!
文中配图除标注外均来自山庄集团
【好酒地理局】原创,欢迎联系授权转载
合作/转载/投稿/咨询,公众号回复关键词
15688579119(手机同微信)